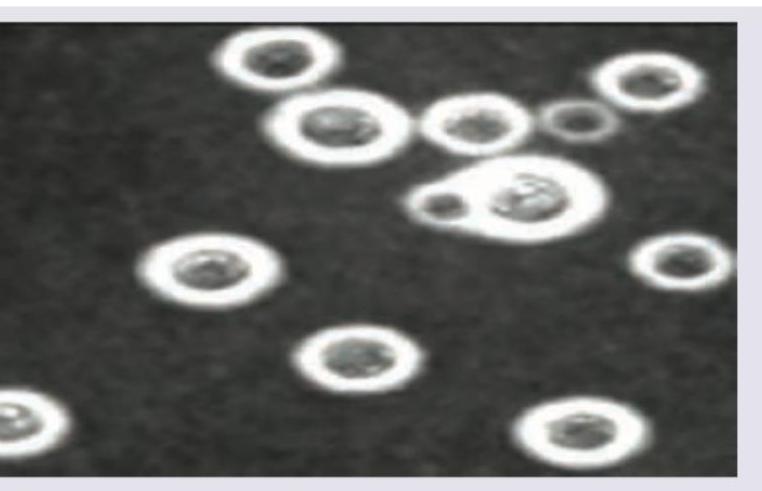
Image for question 6

A 55-year-old woman presents with persistent cough, fever, and hemoptysis. Sputum shows branching septate hyphae. What is the likely pathogen?
A patient presented with some unknown fungal infection. Microscopic examination revealed brown coloured spherical fungi with septate hyphae. Possible condition:
Broad-based budding yeasts are seen in:
What type of spore is produced by Ascomycota during sexual reproduction?
Aseptate hyphae is not seen in which of the following fungi?
All are correct about the image shown except:
Beta 1,3 Glucan test is positive in all except?
Which statement is false regarding Cryptococcus neoformans?
Which of the following is a non-culturable fungus?
Which of the following is not a fungal infection?
Get full access to all questions, explanations, and performance tracking.
Scan to download app